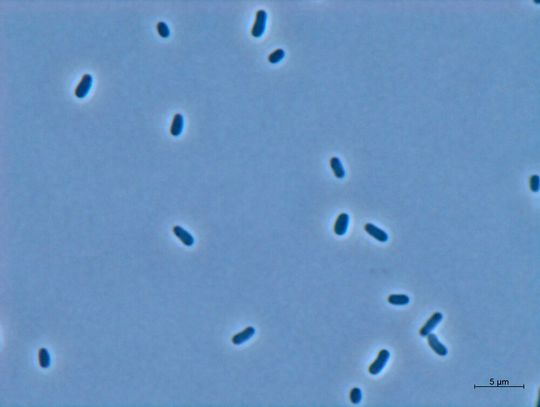
Das ist der winzige Rohstoff-Produzent! Das gram-negative Bakterium Methylobrum extorquens AM1.

Klimagas-Fraß Mikroorganismen machen aus CO2 Polymer-Bausteine
Das von Experten als klimaschädlich eingestufte Kohlendioxid muss reduziert werden. Forschende des Fraunhofer-IGB in Stuttgart haben nun eine bakterienbasierte Antwort, auf die Frage: Wie?
Anbieter zum Thema

Eine quasi winzige, aber schlagkräftige, Antwort auf die Frage, wie man CO2 reduzieren kann, haben Forschende am Fraunhofer-Institut für Grenzflächen- und Bioverfahrenstechnik (IGB) untersucht. Das Bakterium Methylorubrum extorquens AM1 ist nämlich über Umwege in der Lage, aus Kohlendioxid Kunststoff-Vorprodukte zu machen, heißt es.
Mikroorganismen als sparsame Mini-Chemiereaktoren
Dazu verfolgen die Experten, wie es weiter heißt, zwei Ansätze: Erstens die sogenannte heterogene chemische Katalyse, bei der wir das Klimagas per Katalysator zu Methanol umgewandelt wird. Und zweitens die Elektrochemie, mit der aus CO2 Ameisensäure produziert werden kann. Die Besonderheit liegt jedoch nicht allein in dieser CO2-basierten Methanol- und Ameisensäureherstellung, sondern in der Kombination mit der Biotechnologie, genauer gesagt mit Fermentationen durch Mikroorganismen.
Einfacher gesagt, stellen die Stuttgarter aus dem klimaschädlichen Abfallprodukt CO2 zunächst einmal Methanol und Ameisensäure her. Die dann als „Futter“ für Mikroorganismen (siehe oben) dienen. Die Winzlinge machen daraus weitere Produkte, wie etwa organische Säuren, die als Bausteine für Polymere verwendet werden. Wie die Experten betonen, könnte man so auch CO2-basierten Kunststoff herstellen. Auch Aminosäuren lassen sich so produzieren, die etwa als Nahrungsergänzungs- oder Futtermittel genutzt werden können. Wie es weiter heißt, können auch völlig neue Produkte entstehen, oder es kann auch der CO2-Fußabdruck klassischer Produkte verbessert werden. Während übliche chemische Prozesse außerdem viel Energie und teilweise toxische Lösungsmittel benötigen, ließen sich die Produkte per Mikroorganismen bei milderen und sparsameren Bedingungen herstellen, denn, so wird angemerkt, wüchsen die Mikroben in umweltfreundlicheren, wässrigen Lösungen.
Das Zauberwort heißt „Metabolic Engineering“
Dabei nutzen die Forschenden nicht nur nativ-methylotrophe Bakterien – also solche, die von Natur aus Methanol verwerten –, sondern auch Hefen, die eigentlich kein Methanol verstoffwechseln können. Auch behalte man stets im Blick, ob neue interessante Organismen entdeckt werden, um zu überprüfen, ob diese als „Zellfabrik“ taugen. Im Prinzip nutzt man den Stoffwechsel des betreffenden Mikroorganismus, um die Produktherstellung zu steuern, heißt es genauer. Dafür bringen man Gene in die Mikroben ein, die den Bauplan für bestimmte Enzyme liefern – das nennt sich dann Metabolic Engineering. Die Enzyme, die dann im Mikroorganismus produziert werden, katalysieren wieder die Herstellung eines bestimmten Produkts. Und Gene, die diese Produktion negativ beeinflussen könnten, schaltet man gezielt aus.
Das Forscherteam arbeitet an der gesamten Herstellungskette: Angefangen bei den Mikroorganismen über die Genveränderungen bis hin zum Hochskalieren der Produktion. Während einige Herstellungsprozesse noch im Laborstadium seien, würden andere Produkte bereits in ersten Bioreaktoren mit einem Fassungsvermögen von 10 Litern hergestellt. Was die industrielle Anwendung solcher Prozesse angeht, so sehen die Experten eher einen mittel- bis langfristigen Zeithorizont.
(ID:47554185)